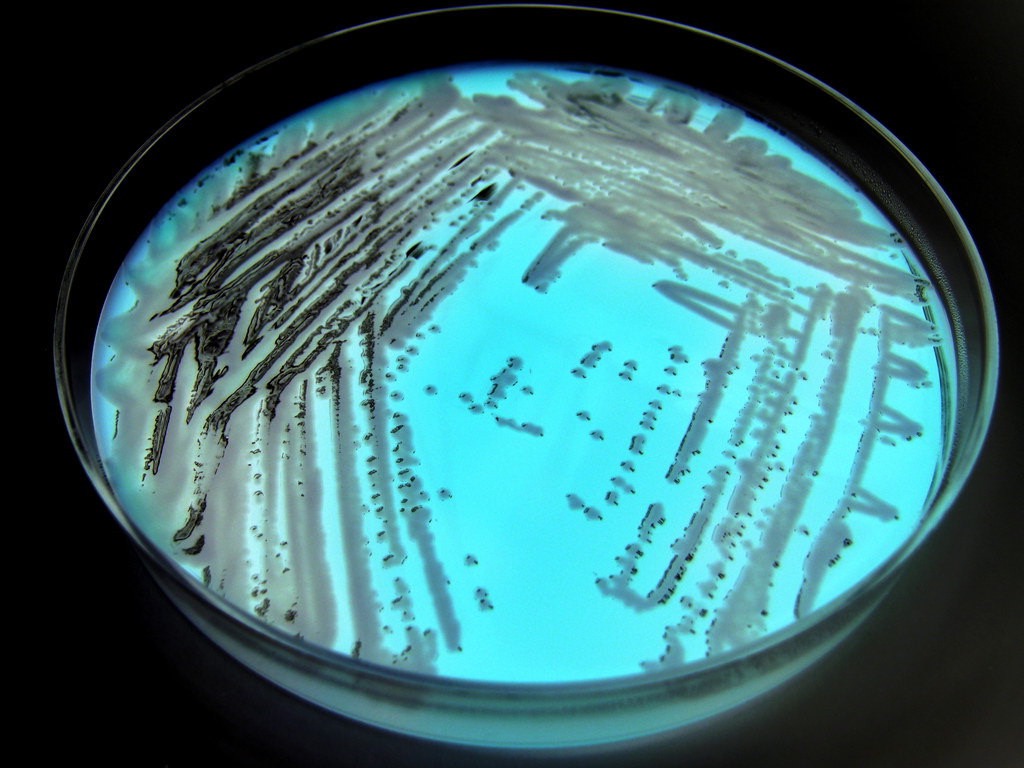

Stenotrophomonas maltophilia Vaccines
Creative Biolabs is a forward-looking research institute as well as a leading custom service provider in the field of vaccine development. With our extensive experience and advanced platform, we have won good reputation among our worldwide customers for successfully accomplishing numerous challenging projects in vaccine development services for Stenotrophomonas maltophilia. We guarantee the finest results for our customers all over the world.
Stenotrophomonas maltophilia is a Gram-negative, motile, nonfermentative bacterium which causes a number of infections, including bacteremia, pheumonia, ocular infection, meningitis, urinary tract infection, and soft tissue infection as well as endocarditis. Recent studies show that it is an emerging multidrug-resistant opportunistic pathogen which causes millions of infections in immunocompromised individuals each year, with high morbidity and mortality rates in most countries around the world. It is a common environmental bacterium which can be found in a variety of aqueous habitats, such as soil, water, contaminated medical solutions and medical devices. Stenotrophomonas maltophilia vaccine development has been a persisting global burden and considerable public health challenge for disease therapy.
The OMPs for Stenotrophomonas maltophilia Vaccines
Stenotrophomonas maltophilia is a common nosocomial and multidrug resistance pathogen in humans, which leads to a series of the upper and lower respiratory tracts infections. It is necessary for vaccine development that prevents both respiratory infection and extra-respiratory spread of S. maltophilia in human. Stenotrophomonas maltophilia is usually diagnosed by laboratory testing, like blood test, cerebrospinal fluid test, or pleural fluid test. S. maltophilia vaccine development has received much attention.
The outer membrane proteins (OMPs) of S. maltophilia are one of the most immunogenic and highly conserved candidates for vaccine development. The data show that a number of the outer membrane proteins and adjuvants of S. maltophilia have been found and widely used in candidate vaccine development, including natural adjuvants Propolis (Pro), FIG polysaccharide (Fcps), Glycyrrhizine (Gly). The results indicate that these OMPs of S. maltophilia have shown an enhanced immune response and resistance against infections in aquaculture. Meanwhile, studies also demonstrate that MopB could be a potential candidate for S. maltophilia vaccine development. MopB is most abundant outer membrane protein in S. maltophilia and the mutant (SmMopB) can significantly reduce the cytotoxicity caused by L929 fibroblasts. In addition, recent studies suggest that the recombinant Smlt4123 has the potential to protect mice from S. maltophilia infection and it should be a candidate for vaccine development.
The Strains for Stenotrophomonas maltophilia Vaccines
The diversity of S. maltophilia strains have been a common issue for vaccine development. There are 52 isolates of S. maltophilia found in human. most of which were isolated from respiratory tract secretions of pneumonia patients, including R551-3, K279a. S. maltophilia G2 and JCMS. JCMS is isolated from soil samples and S. maltophilia R551-3 is usually isolated from laboratory culture. The studies show that different strains of S. maltophilia play different roles in immune response in human. For instance, S. maltophilia G2 is considered as a novel virulence serine protease in regulating nematicidal activity. JCMS can evade the downstream effects of DAF-2/16 pathway components. In this condition, an ideal vaccine should be providing a full range of protective immunity against infections for all these S. maltophilia strains. Research conducted on the understanding of different immunity functions of S. maltophilia strains should be necessary for vaccine development in the future.
Our Services for Stenotrophomonas maltophilia Vaccines
Our platform provides the state-of-art services for any Stenotrophomonas maltophilia vaccines development project. Our scientists specialized in vaccine studies will work with you to develop the most appropriate strategy that will offer the most meaningful data for your research.
- One-stop vaccine development solution
- Cost-saving discovery strategy
- Mature vaccine technology platform
Creative Biolabs is recognized as the world leader for providing vaccine development services for years. We have developed efficient protocols for Stenotrophomonas maltophilia vaccines development. If you are interested in our services, please contact us for more details.
All of our products can only be used for research purposes. These vaccine ingredients CANNOT be used directly on humans or animals.


